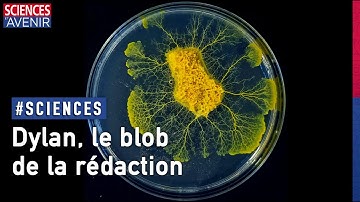
Voici Dylan, le blob de la rédaction !

⬇ DOWNLOAD NOW
Kalau muncul iklan pop-up, tutup lalu klik tombol kembali
Download lagu Pétri express, et transfert de Blob. J+3 - Blob 4 secara gratis hanya untuk keperluan promosi. Dukung artis favorit kamu dengan membeli musik original di iTunes atau platform resmi lainnya.
 Pourquoi le blob fascine les scientifiques
Pourquoi le blob fascine les scientifiques
 Le blob dans un labyrinthe.
Le blob dans un labyrinthe.
 Slime mould solves maze: original video
Slime mould solves maze: original video
 Les derniers jours d'exploitation des Be 4/8 003 et 004 de l'Orbe-Chavornay (Travys)
Les derniers jours d'exploitation des Be 4/8 003 et 004 de l'Orbe-Chavornay (Travys)
 Crane BLOB Launching Is EPIC!!
Crane BLOB Launching Is EPIC!!
Voici Dylan, le blob de la rédaction !
Voici Dylan, le blob de la rédaction !
 27104 E & 083 Hexafret en cv Bachés et Citernes Le Bourget ➡️ Woippy + Double Sifflets voilà
27104 E & 083 Hexafret en cv Bachés et Citernes Le Bourget ➡️ Woippy + Double Sifflets voilà
 Comment découper un blob (Physarum polycephalum)
Comment découper un blob (Physarum polycephalum)